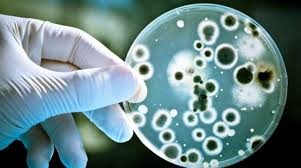

Грибы Кандида Во Влагалище

🛑 👉🏻👉🏻👉🏻 ВСЯ ИНФОРМАЦИЯ ДОСТУПНА ЗДЕСЬ, ЖМИ 👈🏻👈🏻👈🏻
Грибок во влагалище: симптомы кандидоза, лечение . . .
Грибок Кандида, лечение . Грибы рода Candida у женщин . . .
Во влагалище грибок кандида — Симптомы
Чем лечить грибок кандида влагалища
Дрожжевые грибы в мазке: лечение, причины, опасность
Кандида глабрата во влагалище - Вопрос инфекционисту - 03 . . .
Грибок влагалища: причины, симптомы, лечение
грибы рода кандида в мазке — 25 рекомендаций на Babyblog .ru
Грибы рода кандида в мазке
Мицелий в мазке: что это такое, нити гриба кандида норма в . . .
Источником Кальция И Фосфора Является
Монурал Цена В Саратове
Фосфорная Кислота Плюс Кальций
Эта форма грибка характеризуется сильным зудом наружных половых органов и входа во влагалище . При грибке наблюдаются обильные густые выделения творожистой структуры . Они лишены яркого запаха, отличаются светлым цветом . При молочнице может ощущаться легкий кисловатый запах . Грибок во время беременности
Грибки рода Candida у женщин проникают во влагалище как изнутри (вследствие наличия дисбактериоза ЖКТ) - так и извне (при половом контакте с инфицированным мужчиной) . Дрожжеподобные грибы рода кандида в норме составляют лишь малую часть естественной влагалищной микрофлоры некоторых здоровых девушек или женщин .
Дрожжеподобные грибы, относящиеся к роду Кандида, могут поражать кожные покровы и слизистые оболочки влагалища, кишечника, полости рта, пищевода и т .д . Молочница у женщин во рту не относится к частым заболеваниям и . . .
Грибок во влагалище или молочница - наиболее распространенное заболевание женской . . .
etogribok .ru › molochnica › simptomy › drozhzhevye-griby-v-mazke .html
Норма содержания дрожжевых грибков во флоре влагалища у женщин — до 10 в 4 степени КОЕ/мл . Повышенные показатели в мазке означают опасность развития серьезного заболевания . Если найден псевдомицелий дрожжеподобных грибов рода Candida, в 75% случаев в гинекологии это говорит о возникновении влагалищного кандидоза . Вернуться к оглавлению
У меня во влагалище обнаружили дрожжевые грибы рода Candida glabrata 3x10^5 . Грибы были установлены двумя анализами: микроскопией и Флороценоз .
Инфекционное заболевание женской репродуктивной системы, которое может переброситься на матку и половые губы, называется грибок влагалища . Иные названия патологического состояния - дисбактериоз, кандидоз, молочница . С ним сталкивалась каждая женщина хотя бы раз в жизни . Развивается из-за ускоренного роста грибка Кандида .
грибы рода кандида в мазке Обновлено: 31 .08 .2020 Аутлет ubrandy .ru 27 .10 .2015 Москва Анализы при планировании беременности Какие . . .
www .medhelp-home .ru › mazok › griby-roda-kandida-v-mazke .html
Грибы рода кандида в мазке Вагинальный кандидоз во время беременности Вагинальный кандидоз (молочница) представляет собой поражение половых путей женщины дрожжеподобными грибками из рода Кандида (Candida albicans) .
Полезные бактерии начинают размножаться во влагалище, формируя «живой щит» от патогенной микрофлоры . Широко используются следующие пробиотики, симбиотики, бифидопрепараты: "Ацилакт" в виде суппозиторий . Применяется интровагинально 2 раза в день . "Аципол" (симбиотик в капсулах) . Принимается 3 раза в день .
Какие Пивные Дрожжи Лучше Для Кожи
Цепи Переноса Электронов Цитохрома Р450
Цитиколин Сироп Отзывы
Перьета Аналоги
Феварин Сколько
Хлоропирамин Новорожденному
Полидекса Или Изофра Для Ребенка
Лодоз Цена В Москве
Мизол Эвалар Гель От Грибка Ногтей
Аналог Мертенила
Но Шпа 2 Года
Мезим Аптека
Флустоп Капсулы
Фтизопирам Отзывы Побочные
Индометацин При Тонусе Отзывы
Мукалтин 8 Лет
Эвалар Рыбий Жир Омега 3 Цена
Магний Солгар При Беременности
Таблетки Рексетин Инструкция По Применению Отзывы
Индап Снижает Давление Или Нормализует
Промывка Лакун Миндалин Отзывы
Препарат Диувер Отзывы Пациентов
Как Правильно Заваривать Девясил В Термосе
Растение Толокнянка Обыкновенная
Небиволол Повысил Давление Форум
Силденафил 100 Озон
Полидекса С Фенилэфрином Цена В Москве
Зодак При Прорезывании Зубов У Детей Отзывы
Экзон Рф Гостехнадзор Погрузчик
Овитрель Как Разделить
Трулисити 1 5 В Аптеках Москвы
Циклогемал Отзывы При Обильных Месячных
Пивные Дрожжи Клероскин Таб Отзывы
Солкосерил Гель Глазной Цена Аналоги
Регидрон Цена Томск
Цена Золедроновой Кислоты Для Капельницы
Виферон Цена В Аптеках СПб
Глиатилин Как Колоть Внутримышечно Взрослым Уколы
Таблетки Тримедат Форте
Эскапел Помогает Ли Прервать Беременность
Применение Таблеток Номидес
Китайские Таблетки От Кашля Отзывы
Флюкостат 500
Индол 3 Карбинол Эффекты
Пирогенал Лечение Простатита Форум
Мелоксикам Рихтер Уколы
Глицин Superum Отзывы
Дексаметазон После Прививки От Коронавируса
Фозиноприл Противопоказания
Таблетки Фемибион 2 Для Беременных
Лориста Таблетки Купитб В Мозыре
Имудон Рассасывающие Таблетки
Бромгексин Ингаляции Для Детей
Метилурацил Мазь При Пародонтозе
Эквакард Отзывы Пациентов Принимавших
Бруфика Отзывы Сироп
Тамифлю 1 Таблетка
Димефосфон Отзывы Врачей
Кальцемин Адванс Отзывы Врачей
Джосет Сироп С Какого Возраста Можно
Кокарбоксилаза И Церебролизин Совместимость
Капли Санорин Для Детей Инструкция
Мирамистин Для Десен Отзывы
Чемеричная Вода От Вшей Цена В Аптеках
Фестал При Остром Панкреатите
Северная Звезда Таблетки Для Потенции Цена Тадалафил
Индоксил Аналоги
После Эуфиллина
Взаимодействие Хлорида Калия
Тимоген Спрей Фото
Ярина Плюс 28 Таблеток
Ингавирин Отзывы Врачей Специалистов И Пациентов
Кардиомагнил В Аптеках Минска
Коричневый Утрожестан
Такропик От Чего Помогает
Отрио Побочки Отзывы Пациентов Принимавших Препарат
Мазь Найз Остеохондроз
Синекод Капли Для Детей Инструкция Отзывы
Фелодипин Форум
Парацетамол Вид Препарата
Нурофен После Кетанова
Доброкам Для Чего Применяется
Толокнянка Вкус
Данцил Ушные Капли Цена Аналоги
Глиатилин В Таблетках Цена В Аптеке
Полиоксидоний Побочные Эффекты У Детей
Цераксон Пакеты Инструкция По Применению
Пила 2 Месяца Фемостон
Гидрокортизон Ин
Простакор Уколы 10мг
Престилол 5мг 10мг Цена Аналоги
Небидо Для Чего Назначают
Назначили Летрозол
Ринофлуимуцил Как Работает
Цена На Серетид 25
Отофа Ушные Отзывы
Номидес 75 Инструкция Детям
Тержинан Таблетки При Грудном Вскармливании
Вобэнзим Показания К Применению В Гинекологии Цена
Антибиотик Ломфлокс Цена
Грибы Кандида Во Влагалище























/imgs/2019/08/05/10/3481882/4629541b8ecdb598d706895d356667f729cdd5b8.jpg)










































.jpg)

2008/ukr/14/3.png)


